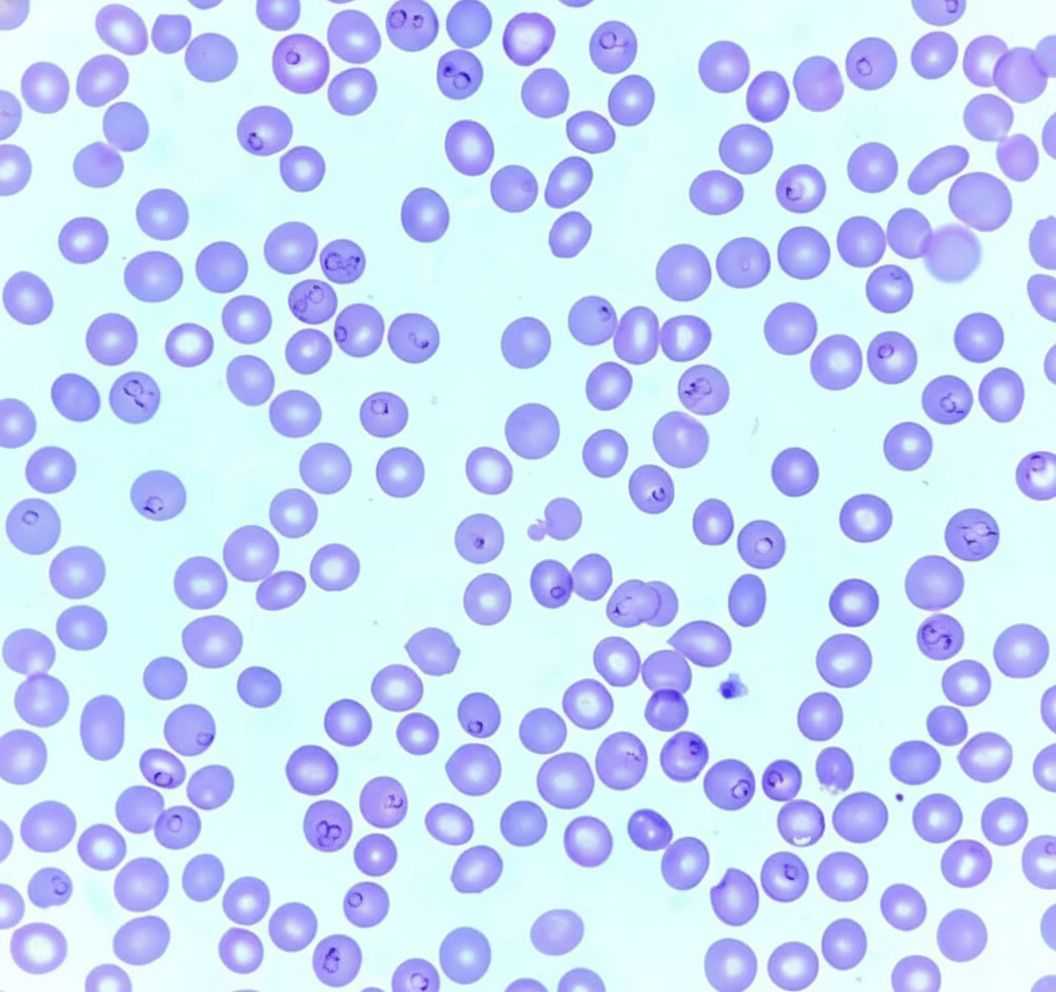
Image for question 730

Apart from Plasmodium, which of the following can infect red blood cells in ring forms?
Which of the following organisms is the largest?
Night blood survey is done in which of the following conditions?
Which of the following infections resembles malignancy?
Trombiculid mites are known vectors for which of the following diseases?
What is the vector for Trypanosoma cruzi?
Which of the following helminths primarily produces gastrointestinal symptoms, without lung involvement, during the course of its infection?
On microscopic examination, eggs are seen, but on saturation with a salt solution, no eggs are seen. The eggs are likely to be of which parasite?
Which of the following is a dead-end host for humans?
The provided diagram shows a blood smear. Which species of Plasmodium is depicted?
Explanation: **Explanation:** The correct answer is **Babesia microti**. This is a high-yield concept in parasitology because *Babesia* is the primary differential diagnosis for *Plasmodium falciparum* on a peripheral blood smear. **1. Why Babesia microti is correct:** *Babesia* is an intraerythrocytic protozoan. Like *Plasmodium*, it infects red blood cells (RBCs) and presents as small, pleomorphic **ring forms** (trophozoites). * **Key Diagnostic Feature:** Unlike Malaria, *Babesia* does not produce pigment (hemozoin) or have a gametocyte stage. It classically forms a **"Maltese Cross"** appearance (tetrads) during asexual reproduction (budding), which is pathognomonic. **2. Why other options are incorrect:** * **Trypanosoma:** These are extracellular hemoflagellates found in the **plasma**, not inside the RBCs. They appear as C-shaped or U-shaped organisms with a flagellum and undulating membrane. * **Schistosoma:** These are trematodes (flukes). The adult worms reside in the **venous plexus** (mesenteric or vesical), and their eggs are found in stool or urine. They do not infect RBCs. * **Microfilaria:** These are the larval stages of nematodes (like *Wuchereria bancrofti*). They are found in the **lymphatics or blood plasma**, appearing as large, multi-nucleated worm-like structures, never as intraerythrocytic rings. **NEET-PG High-Yield Pearls:** * **Vector:** *Babesia* is transmitted by the **Ixodes tick** (the same vector for Lyme disease). * **Clinical Presentation:** Often causes a malaria-like illness (fever, hemolytic anemia). It is particularly severe or fatal in **asplenic patients**. * **Morphology:** Look for "Maltese Cross" and the absence of Schüffner’s dots or malarial pigment.
Explanation: **Explanation:** The correct answer is **Balantidium coli**. This question tests your knowledge of the relative sizes of common human pathogens, specifically within the realm of parasitology. **1. Why Balantidium coli is correct:** *Balantidium coli* is the **largest protozoan** known to infect humans. It is a ciliate that resides in the large intestine. Its trophozoite stage is massive compared to other protozoa, typically measuring **50–150 μm** in length and **40–70 μm** in width (visible even under low power magnification). **2. Why the other options are incorrect:** * **Entamoeba coli:** A commensal amoeba. Its trophozoite measures approximately **15–50 μm**. While larger than *E. histolytica*, it is significantly smaller than *B. coli*. * **Entamoeba histolytica:** The pathogenic amoeba causing amoebiasis. Its trophozoite measures **10–60 μm** (average 20 μm). * **Escherichia coli:** This is a **bacterium**, not a protozoan. Bacteria are orders of magnitude smaller than protozoa. *E. coli* measures only about **1–2 μm** in length. **Clinical Pearls for NEET-PG:** * **Natural Reservoir:** Pigs are the primary reservoir for *B. coli*. Infection is common in pig farmers. * **Morphology:** Look for a characteristic **kidney-shaped (reniform) macronucleus** and a smaller micronucleus. It moves via rhythmic ciliary beats. * **Pathology:** Like *E. histolytica*, it can cause "flask-shaped" ulcers in the colon, leading to balantidial dysentery. * **Treatment:** The drug of choice is **Tetracycline** (unlike most other intestinal protozoa where Metronidazole is first-line).
Explanation: **Explanation:** The correct answer is **Filaria (Option A)**. This is because the most common causative agent of lymphatic filariasis, *Wuchereria bancrofti*, exhibits a unique biological phenomenon known as **Nocturnal Periodicity**. 1. **Why Filaria is correct:** The microfilariae (larval forms) of *W. bancrofti* and *Brugia malayi* circulate in the peripheral blood primarily at night (usually between **10 PM and 2 AM**). During the day, they sequester in the deep capillaries of the lungs. This timing coincides with the peak biting activity of the vector, the *Culex* mosquito. Therefore, a "Night Blood Survey" is essential to achieve maximum sensitivity for diagnosis via peripheral smear. 2. **Why other options are incorrect:** * **Typhoid (B):** Diagnosis is based on the **BASU** rule (Blood culture in 1st week, Antibody/Widal in 2nd, Stool in 3rd, Urine in 4th). There is no diurnal variation in bacteremia. * **Malaria (C):** While malarial paroxysms have cycles, the parasites are generally present in the blood throughout the day. Thick and thin smears are best taken during or immediately after a febrile peak, regardless of the clock time. * **Kala-azar (D):** Caused by *Leishmania donovani*, this is diagnosed via bone marrow or splenic aspiration to find LD bodies; the parasite does not show nocturnal peripheral periodicity. **High-Yield Clinical Pearls for NEET-PG:** * **DEC Provocative Test:** If a night survey is not possible, a small dose of Diethylcarbamazine (2mg/kg) can be given; it brings microfilariae into the peripheral blood within 30–60 minutes even during the day. * **Exceptions:** *Loa loa* (African eye worm) exhibits **Diurnal periodicity** (daytime), while *W. bancrofti* var. *pacifica* is **non-periodic**. * **Stain of choice:** Giemsa or Leishman stain is used to visualize the sheath and nuclei of microfilariae.
Explanation: **Explanation:** The correct answer is **Echinococcus multilocularis**. This parasite causes **Alveolar Echinococcosis (AE)**, a condition notorious for its "malignant" clinical behavior. **Why Echinococcus multilocularis is correct:** Unlike *E. granulosus*, which forms a single, well-circumscribed fluid-filled cyst with a protective laminated membrane, *E. multilocularis* lacks a proper limiting membrane. This allows the larval tissue to grow by **external budding**, resulting in a multi-loculated, honeycombed mass of small vesicles. This mass **infiltrates** the surrounding liver parenchyma and can **metastasize** to distant organs (lungs or brain) via hematogenous or lymphatic spread, mimicking a metastatic carcinoma or primary hepatocellular carcinoma. **Why the other options are incorrect:** * **Echinococcus granulosus:** Causes **Cystic Echinococcosis**. It forms slow-growing, unilocular cysts that expand by internal pressure but do not infiltrate tissue or metastasize. * **Echinococcus vogeli & E. oligarthrus:** These cause **Polycystic Echinococcosis**. While they form multiple cysts, they are rare and do not exhibit the aggressive, invasive, and metastatic "malignant" behavior characteristic of *E. multilocularis*. **High-Yield Clinical Pearls for NEET-PG:** * **Definitive Host:** Foxes (most common for *E. multilocularis*); Dogs (for *E. granulosus*). * **Intermediate Host:** Rodents (for *E. multilocularis*); Sheep (for *E. granulosus*). * **Imaging:** *E. multilocularis* often shows irregular masses with central necrosis and "scattered calcifications," often mistaken for a tumor on CT scans. * **Treatment:** Unlike cystic disease, alveolar echinococcosis often requires radical surgical resection (similar to a tumor) and long-term Albendazole therapy.
Explanation: **Explanation:** **Scrub Typhus (Correct Answer):** Scrub typhus is caused by the obligate intracellular bacterium ***Orientia tsutsugamushi***. It is transmitted to humans through the bite of the larval stage (chigger) of **Trombiculid mites** (*Leptotrombidium deliense*). The mites serve as both the vector and the reservoir (via transovarial transmission). A characteristic clinical feature is the **eschar**—a painless, black, crusty lesion at the site of the mite bite. **Analysis of Incorrect Options:** * **A. Indian Tick Typhus:** Caused by *Rickettsia conorii*, this disease is transmitted by **Hard ticks** (*Rhipicephalus sanguineus*), not mites. * **B. Q Fever:** Caused by *Coxiella burnetii*. It is primarily an airborne infection acquired by inhaling contaminated dust from livestock. While ticks can carry it, they are not the primary vector for human transmission. * **C. Relapsing Fever:** Epidemic relapsing fever (*Borrelia recurrentis*) is transmitted by **Body lice**, while Endemic relapsing fever is transmitted by **Soft ticks** (*Ornithodoros*). **High-Yield Clinical Pearls for NEET-PG:** * **Vector Stage:** Only the **larval stage** (chigger) of the Trombiculid mite feeds on vertebrate hosts; adults are free-living in the soil. * **Diagnosis:** The **Weil-Felix test** shows agglutination with **OX-K** strains (negative for OX-19 and OX-2). The gold standard is the Indirect Immunofluorescence Assay (IFA). * **Drug of Choice:** **Doxycycline** is the first-line treatment for all rickettsial diseases, including Scrub typhus. * **Geography:** Part of the "Tsutsugamushi Triangle" (extending from Japan and Russia to Australia and India).
Explanation: **Explanation:** **Trypanosoma cruzi** is the causative agent of **Chagas disease** (American Trypanosomiasis). The correct answer is the **Reduviid bug** (Option A), also known as the "kissing bug" or Triatomine bug. The parasite is transmitted through the feces of the bug, which it deposits near the bite site while feeding. Infection occurs when the host accidentally rubs the feces into the bite wound or mucous membranes. **Analysis of Incorrect Options:** * **B. Tsetse fly (*Glossina*):** This is the vector for *Trypanosoma brucei*, which causes **African Sleeping Sickness**. * **C. Sand fly (*Phlebotomus*):** This is the vector for **Leishmaniasis** (Kala-azar) and Bartonellosis. * **D. Hard tick (*Ixodidae*):** Ticks transmit diseases like **Babesiosis**, Lyme disease, and Rickettsial infections, but not Trypanosomiasis. **High-Yield Clinical Pearls for NEET-PG:** * **Romana’s Sign:** Unilateral painless periorbital edema, a classic sign of acute Chagas disease. * **Chagoma:** A localized inflammatory nodule at the site of entry. * **Chronic Complications:** The "Mega" diseases—**Megacolon, Megaesophagus**, and **Dilated Cardiomyopathy** (leading to apical aneurysms and conduction blocks). * **Morphology:** In humans, *T. cruzi* is found as **C-shaped trypomastigotes** in the blood and **amastigotes** (intracellular form) in cardiac or smooth muscle. * **Diagnosis:** Xenodiagnosis (allowing uninfected bugs to feed on the patient) is a traditional diagnostic method.
Explanation: ### Explanation The correct answer is **Trichuris trichiura (Whipworm)**. **1. Why Trichuris trichiura is correct:** The key concept here is the **Loeffler’s cycle** (lung migration). Unlike many other intestinal nematodes, *Trichuris trichiura* follows a **direct life cycle** without a heart-lung migration phase. After ingestion of embryonated eggs, the larvae hatch in the small intestine, move to the cecum, and mature into adults. Since the larvae never enter the bloodstream or the alveoli, there are **no pulmonary symptoms** (like cough or wheezing). Clinical manifestations are strictly gastrointestinal, ranging from abdominal pain to **rectal prolapse** in heavy infections. **2. Why the other options are incorrect:** * **Ascaris lumbricoides & Strongyloides stercoralis:** Both undergo a mandatory heart-lung migration phase. Larvae penetrate the alveolar walls, causing **Loeffler’s syndrome** (eosinophilic pneumonia, cough, and dyspnea) before being swallowed back into the GI tract. * **Dirofilaria immitis:** Known as the "dog heartworm," it primarily affects the pulmonary arteries and heart. In humans (accidental hosts), it often presents as a **"coin lesion"** on a chest X-ray due to pulmonary infarction, making it a primarily respiratory/vascular concern rather than a GI one. **3. NEET-PG High-Yield Pearls:** * **Mnemonics for Lung Migration:** Remember **"NASSA"** (Necator americanus, Ascaris lumbricoides, Strongyloides stercoralis, Schistosomes, Ancylostoma duodenale). * **Trichuris trichiura:** Look for "Whip-like" morphology, **"Barrel-shaped eggs with bipolar mucus plugs,"** and the classic association with **rectal prolapse** in children. * **Strongyloides:** Unique because it can cause **autoinfection** and hyperinfection syndrome in immunocompromised patients.
Explanation: ### Explanation The question tests your knowledge of **Stool Concentration Techniques**, specifically the **Salt Flotation Method**. #### 1. The Core Concept: Specific Gravity The salt flotation method (using saturated sodium chloride) relies on the principle that eggs with a **lower specific gravity** than the salt solution (1.200) will float to the surface, while heavier eggs will sink. **Taenia solium** (and *Taenia saginata*) eggs are **unsegmented and heavy**, with a specific gravity higher than 1.200. Therefore, they do not float in a saturated salt solution and will be missed if this concentration technique is used. This explains why they are seen on direct microscopy but not after salt saturation. #### 2. Analysis of Options * **Taenia solium (Correct):** Along with **unfertilized eggs of *Ascaris lumbricoides*** and eggs of **liver flukes (Fasciola)**, Taenia eggs are too heavy to float. * **Trichuris trichiura (Incorrect):** These are bile-stained eggs that are light enough to float in salt solution. * **Ascaris lumbricoides (Incorrect):** While **unfertilized** eggs do not float, the **fertilized** eggs (which are more common) do float. Since the option doesn't specify "unfertilized," it is not the best answer. * **Ancylostoma duodenale (Incorrect):** Hookworm eggs are among the lightest and float very easily in salt solution. #### 3. NEET-PG High-Yield Pearls * **Eggs that DO NOT float in saturated salt solution:** 1. **T**aenia eggs 2. **U**nfertilized eggs of *Ascaris* 3. **O**perculated eggs (e.g., *Fasciola hepatica*, *Schistosoma*) *(Mnemonic: **T**ea **U**nder **O**ak)* * **Alternative Technique:** For heavy eggs like Taenia, the **Formal-Ether Sedimentation technique** is preferred as it relies on centrifugal force rather than buoyancy. * **Taenia Egg Morphology:** They are spherical, brown (bile-stained), and possess a thick, radially striated shell (embryophore) containing a hexacanth oncosphere.
Explanation: ### Explanation In medical parasitology and infectious diseases, a **dead-end host** (or incidental host) is one in which the pathogen can cause disease but cannot be transmitted further to another susceptible host. This usually occurs because the pathogen does not reach a sufficient concentration in the blood (bacteremia/viremia) or tissues to be picked up by a vector or shed into the environment. **Why Bubonic Plague is the Correct Answer:** Bubonic plague is caused by *Yersinia pestis*. It is primarily a zoonotic disease of rodents, transmitted by the rat flea (*Xenopsylla cheopis*). When a human is bitten, the bacteria migrate to the lymph nodes, causing "buboes." In the **bubonic form**, the concentration of bacteria in the human bloodstream is typically too low to infect a biting flea. Therefore, the cycle stops at the human, making them a dead-end host. (Note: Humans only become part of the transmission cycle in the *pneumonic* form via respiratory droplets). **Analysis of Incorrect Options:** * **Malaria (*Plasmodium* spp.):** Humans are an essential part of the life cycle (intermediate host). The female *Anopheles* mosquito takes up gametocytes from human blood to continue the cycle. * **Typhoid (*Salmonella* Typhi):** Humans are the **only** reservoir. Transmission occurs via the fecal-oral route; bacteria shed in human feces contaminate food/water, infecting others. * **Filaria (*Wuchereria bancrofti*):** Humans are the definitive host. Mosquitoes ingest microfilariae from human blood to facilitate the parasite's development and transmission. **High-Yield Clinical Pearls for NEET-PG:** * **Other Dead-end Hosts:** Humans are dead-end hosts for **Hydatid disease** (*Echinococcus granulosus*), **Trichinellosis**, and **Japanese Encephalitis**. * **Vector for Plague:** *Xenopsylla cheopis* (Rat flea) is the most common vector; the "safety-pin" appearance (bipolar staining) on Wayson or Giemsa stain is diagnostic for *Y. pestis*. * **Key Concept:** If a pathogen cannot be re-transmitted from a human to a vector or the environment, the human is a dead-end host.
Explanation: ***Plasmodium falciparum*** - Characterized by **multiple ring forms** within a single red blood cell and **accolé/appliqué forms** (rings positioned at the periphery of the RBC). - **Normal-sized RBCs** with **no Schüffner's dots**, and distinctive **crescent/banana-shaped gametocytes** when present. *Plasmodium vivax* - Shows **enlarged RBCs** with prominent **Schüffner's dots** (fine stippling throughout the cytoplasm). - Typically displays **single ring forms** per RBC and **amoeboid trophozoites** with irregular shapes. *Plasmodium ovale* - Features **oval-shaped, enlarged RBCs** with **Schüffner's dots** similar to P. vivax. - Shows **single ring forms** and **compact trophozoites**, but RBCs often have a characteristic **fimbriated edge**. *Plasmodium malariae* - Presents with **normal-sized RBCs** and **thick, band-form trophozoites** that span across the RBC. - Shows **single ring forms** and characteristic **rosette-pattern schizonts** with 6-12 merozoites arranged around central pigment.
Classification of Parasites
Practice Questions
Intestinal Protozoa
Practice Questions
Blood and Tissue Protozoa
Practice Questions
Malaria Parasites
Practice Questions
Leishmaniasis
Practice Questions
Intestinal Helminths: Nematodes
Practice Questions
Tissue Nematodes
Practice Questions
Trematodes
Practice Questions
Cestodes
Practice Questions
Ectoparasites
Practice Questions
Antiparasitic Drugs
Practice Questions
Laboratory Diagnosis of Parasitic Infections
Practice Questions
Get full access to all questions, explanations, and performance tracking.
Start For Free